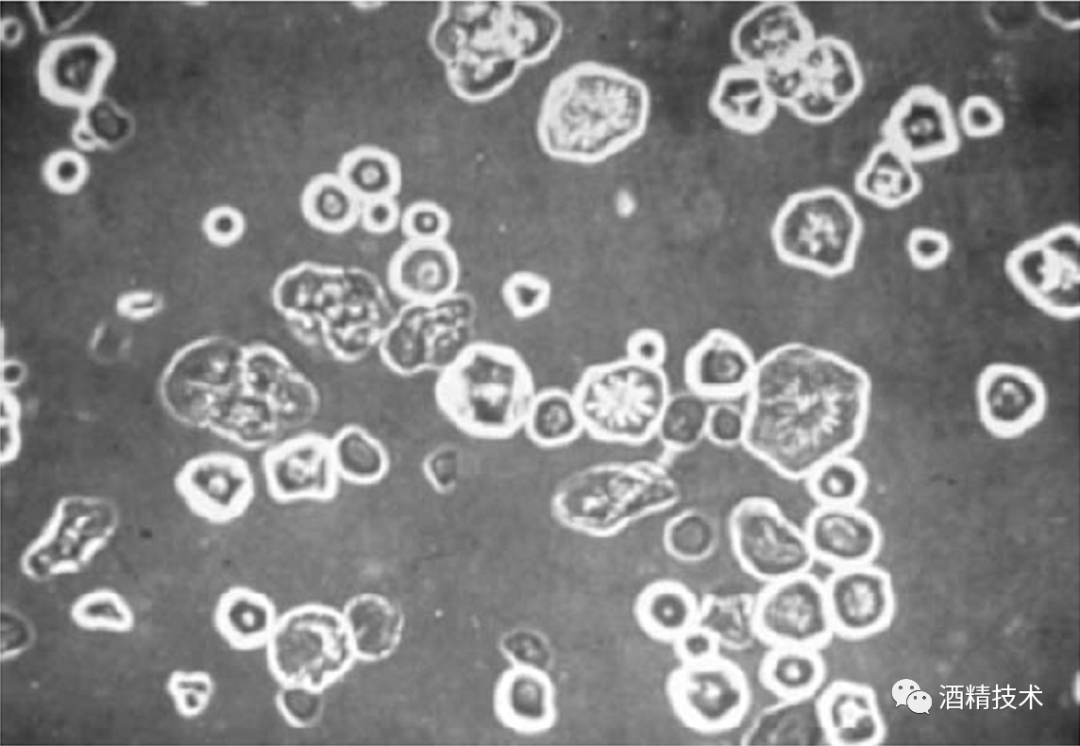

第3章淀粉浆的糊化(蒸煮)、液化与糖化工艺
淀粉的糊化(蒸煮)、液化以及糖化过程是淀粉质原料制取酒精的重要部分,对于后续的发酵有着重要的意义。
3.1淀粉浆糊化(蒸煮)、液化与糖化概述
一般来说,含在原料细胞中的淀粉颗粒,由于植物细胞壁的保护作用,不易受到淀粉酶系统的作用。另外,不溶解状态的淀粉被常规糖化酶糖化的速度非常缓慢,水解程度也不高。所以,淀粉原料在进行液化、糖化之前通常要经过蒸煮,使淀粉从细胞中游离出来、并转化为溶解状态(即糊化),以便淀粉酶系统进行液化糖化作用,这就是原料蒸煮处理的主要目的。当然,蒸煮处理同时可以达到部分杀菌的目的。
糊化之后的淀粉浆要通过酶进行分解,酶解工艺主要包括淀粉的液化和糖化两个步骤。液化是利用液化酶使糊化的淀粉浆粘度降低,并将淀粉水解成糊精和低聚糖;糖化是利用糖化酶将液化得到的糊精和低聚糖彻底水解成葡萄糖,供酵母菌进行呼吸作用产生酒精。也就是说,淀粉质原料液化糖化实际上是淀粉在淀粉酶、糖化酶的作用下,使淀粉水解成葡萄糖的过程,其主反应式如下:

典型的糊化、液化与糖化全流程如图3-1所示。
总之,为将薯类、谷类、野生植物等淀粉质原料中的淀粉水解为可发酵糖类,一般需要经过糊化(水热处理)、液化与糖化三个步骤。
3.2 淀粉浆糊化(蒸煮)、液化、糖化原理
3.2.1糊化(蒸煮)原理
糊化(蒸煮)、液化和糖化的目的是将淀粉水解成可发酵糖类,即先通过α-淀粉酶将淀粉水解为糊精和低聚糖;然后利用糖化酶(淀粉葡萄糖苷酶)水解糊精或低聚糖释放葡萄糖。然而,为了使α-淀粉酶能够顺利和淀粉分子作用,首先必须打破淀粉的颗粒状结构,这一过程称为糊化。当谷物浆与水一起加热时,淀粉颗粒开始吸水膨胀,从而淀粉逐渐失去其晶体结构,变大,形成的凝胶囊往往填补所有可用空间,胶凝作用最高点也是糊状物的最大粘稠点。图3-2 ,3-3和3-4显示的是玉米淀粉逐步糊化,图3-1中的颗粒与周围的液体中的边界相当清楚,可以很容易地与周围液体相分辨;图3-2中相同的颗粒已经产生了一定规模的膨胀,即一些液体已进入颗粒;图3-3显示的是颗粒已经成为模糊的实体,液体已经大量进入颗粒,颗粒已扩大到了相当大的规模。

图3-1 糊化、液化与糖化全流程示意图
一般来说,淀粉以颗粒形态存在于谷物种子、薯类块根(甘薯)块茎(马铃薯)的细胞内,各种作物中的淀粉含量因品种、成熟度、气候、土质及其它生长环境不同而异。
淀粉颗粒呈白色,不溶于冷水和有机溶剂,淀粉颗粒内呈复杂的结晶组织,不同原料的淀粉颗粒具有不同的形状和大小,大体上分为圆形、椭圆形和多角形。
淀粉颗粒具有抵抗外力作用较强的外膜,其化学组成与内层淀粉相同。但由于水分较少,密度较大,故强度较大。淀粉颗粒是由许多针状小晶体聚合而成的,而小晶体则是由淀粉分子链之间靠氢键的作用联结而成的。
图3-2 显微镜中67
℃时糊化的玉米淀粉颗粒 (在正常照明下)

图3-3 显微镜下75 ℃糊化的玉米淀粉颗粒(正常照明)

图3-4 显微镜下85 ℃糊化的玉米淀粉(正常照明)
淀粉属亲水胶体,遇水后,水分子在渗透压作用下,渗入淀粉颗粒内部使淀粉分子的体积和重量增加,这种现象称作膨胀。淀粉在水中加热,即发生膨胀。这时淀粉颗粒好像是一个渗透系统,其中支链淀粉起着半渗透膜的作用,而渗透压的大小及膨胀程度则随温度升高而增加。从40℃开始膨胀的速度明显加快。当温度升高到60~80℃时,淀粉颗粒的体积可膨胀到原体积的50~100倍,淀粉分子间的结合削弱,引起淀粉颗粒的部分解体,形成均一的粘稠液体,这种无限膨胀的现象称为淀粉的糊化,对应的温度称为糊化温度。
糊化温度与淀粉颗粒大小、水中盐分含量等有关。由于任何原料的淀粉颗粒大小都不均一,所以糊化温度应该是一个温度范围(从糊化开始到结束)。表3-1给出了不同作物淀粉颗粒的大小,以及糊化液化温度。
对于各种粉碎原料来说,其糊化温度要较相应品种的纯淀粉高一些。因为原料中存在的糖类、含氮化合物、电解质等物质会降低水的渗透作用,从而使膨胀作用速度变慢。
淀粉在糊化过程中最明显的物理性状变化是醪液黏度的变化,变化情况如图3–5所示。
表3–1 不同作物淀粉颗粒大小、糊化和液化温度(℃)
作物种类 | 颗粒大小(µm) | 糊 化 温 度 | 液 化 温 度 | ||
初 始 | 中 点 | 终 结 | |||
玉 米 | 5~25 | 62.0 | 67.0 | 72.0 | 146~151 |
小 麦 | 2~45 | 58.0 | 61.0 | 64.0 | 136~141 |
马 铃 薯 | 15~100 | 50.0 | 63.0 | 68.0 | 132 |
木 薯 | 5~35 | 52.0 | 59.0 | 64.0 | |
大 米 | 3~8 | 68.0 | 74.5 | 78.0 | |
大 麦 | 5~40 | 51.5 | 57.0 | 59.5 | |
黑 麦 | 5~50 | 57.0 | 61.0 | 70.0 | 121~127 |
高 粱 | 5~25 | 68.0 | 73.0 | 78.0 | |

淀粉浆液加热到35~45℃时,醪液黏度略有下降(图中a区域),继续升温,黏度缓慢回升。当温度达到75~85℃时,醪液黏度急剧上升,到90℃时达到顶点(图中b区域),再进一步提高温度,黏度又开始迅速降低(图中c区域)。由图可见,b区域是糊化区,与图中1,2相对应的t1和t2则是糊化温度范围;c区域为高温液化区。
可用氢键理论来解释淀粉的糊化和高温液化现象。温度升高,淀粉颗粒中大分子间氢键结合减弱,造成淀粉颗粒部分解体,形成网状组织,发生糊化现象。如果温度继续上升并达到120℃以上时,升温能量破坏了水分子和淀粉分子之间的氢键,醪液胶体状态遭到破坏,黏度下降,即发生高温液化现象。
高温液化了的淀粉醪液在温度降低时,黏度会逐步增加。降到60℃时,变得非常黏,到55℃以下会变成凝胶,时间一长,则会重新产生部分结晶,这种现象称为淀粉糊化醪的“反生”。
反生现象是由于淀粉分子之间氢键的重新形成引起的。变成凝胶后的醪液无法输送,更不能与糖化酶充分混合,造成生产停顿。为此,在生产上,高温液化了的糊化醪应尽快冷却到60~65℃,并立即与糖化酶混合,进行糖化作用,使淀粉变成糖或分子较小的糊精,以防止反生现象发生。特别是在糊化过程中发生较长时间的停电、停气等事故时,一定要果断采取措施,将糊化醪送入糖化罐,进行糖化,不能让糊化醪长时间停留在蒸煮罐中。
目前,出于节能和工艺(高温液化了的糊化醪易于反生)方面的考虑,较少采用高温蒸煮,液化过程主要通过淀粉酶实现。因此蒸煮过程往往只进行到糊化阶段,而不再进行到高温液化阶段。
3.2.2液化原理
液化是通过α-淀粉酶对淀粉分子的作用完成的。淀粉以两种形式存在。一种形式是直链淀粉,那里葡萄糖单位是通过α- 1,4糖苷连接的(图3-4) 。玉米的直链淀粉含量约为淀粉总数的10%;直链淀粉链长度多为200~1000个葡萄糖单位,最近发现长度可达2000甚至6000个葡萄糖单位的直链淀粉。其他形式的淀粉被称为支链淀粉,约占玉米中淀粉的90%。支链淀粉的分支结构如图3-5所示。支链淀粉不仅具有与直链淀粉相同的α- 1,4糖苷联接,而且还有通过α- 1,6连接的分支结构。分枝点之间平均有5~8个葡萄糖单位,支链中的葡萄糖单位仍是α–1,4键连接,支链长度平均为25个葡萄糖单位。在支链淀粉中葡萄糖单位的数量可高达10000。三种最普通的乙醇生产原料,玉米,小麦和高粱中的淀粉分子大小是类似的,但直链淀粉和支链淀粉含量的百分比不同。



直链淀粉溶于水后形成粘度不高的溶液,支链淀粉只有在一定温度下才溶于水,并生成粘性溶液;碘液可使直链淀粉变蓝,支链淀粉则变成紫红色。
α-淀粉酶可随机地与直链淀粉和支链淀粉分子中的与α–1,4 糖苷作用,并切断α–1,4 糖苷键,但不会切断α- 1,6糖苷键。由此产生的短直链(低聚糖)淀粉称为糊精,而短支链淀粉被称为α-极限糊精。混合糊精的粘度很小。
3.2.3糖化原理
糖化是从液化的混合糊精中释放单个的葡萄糖分子,糊精具有不同的链长,而且链长越短,胞外糖化酶就越容易发挥作用,这是因为糖化酶先从链状糊精分子的非还原端开始,连续水解α- 1 ,4糖苷键,从而释放单葡萄糖分子,链长越短,该过程进行得越快。糖化酶也水解α- 1,6糖苷键,但速度比较慢。因此糖化酶发挥作用的程度和糊精链的长度直接相关,但目前尚不知道如何妥善的使α-淀粉酶生产出更多的小分子低聚糖。
3.2.4 与液化糖化有关的酶类及其特性
我国古代是用天然微生物制剂“大曲”来生产曲酒的。但是,酒精生产中长期以来是以大麦芽等谷芽作为糖化剂的。19世纪末,出现了“阿米诺”酒精生产法,采用的微生物是毛霉和根霉。20世纪初,日本首先研究成功利用黄曲霉来生产高峰淀粉酶,开创了表面培养,生产固体曲作为糖化剂的时代。实践证明,微生物来源糖化剂的性能优于麦芽。整个50年代我国在生产麸曲用的菌株和生产方法上进行了许多研究和改进,取得了明显的进展。50年代末,60年代初,国内外开始广泛采用液体深层通风培养曲霉菌,以生产液体曲来代替固体曲,随后又出现了将液体培养液中的淀粉酶进行浓缩或沉淀出来。制成浓缩酶液或干酶制剂出售,这就是糖化酶的来由。总之,糖化剂种类的演变可用下面的进程表示:
麦芽 → 木盒曲 → 帘子曲 → 通风制曲 → 液体曲 → 糖化酶
酶制剂工业的兴起,始于19世纪日本人高峰让吉开设的生产黑曲霉淀粉酶的工厂,至今已有100多年的历史。到目前为止,已经在自然界中发现的酶有2500多种,申请专利的酶制剂有100多种,其中有经济价值的仅有60多种,而工业化生产的酶制剂只有约20种,占已知酶的0.8%。
在全球酶制剂总产量中,有55%是水解酶,主要用于酒精、淀粉加工、酿酒、焙烤食品和纺织等工业中;有35%是蛋白酶,主要用于洗涤剂、制革和乳品工业;其余是药用酶制剂、试剂级酶制剂和工具酶。
在世界酶制剂工业中,丹麦的NOVO公司几十年来一直处于世界领先地位,该公司以产品品种齐全、质量优良著称。美国Genencor公司在1996年兼并Gist Brocades公司工业用酶部分和1997年兼并Salvay公司(原Miles公司)后跃居世界第二。世界酶制剂市场已由多极化竞争转向大公司之间的竞争。
我国的酶制剂工业是从1965年无锡酶制剂厂建成投产开始的,20世纪80年代后陆续建成一些小厂,主要是生产单一的干粉剂型糖化酶供应酿酒厂。国内目前仍以无锡酶制剂厂(无锡星达生物工程有限公司)生产的产品品种较多,质量较好。但我国酶制剂生产的总体水平与国际先进水平尚有一定的差距,表现在品种单一,且多是淀粉酶系列品种(糖化酶产品的产量占国内酶制剂总产量的50%~60%)。近年来,国外酶制剂公司的介入,给我国酶制剂的生产带来了活力,同时也带来了挑战。1998年,在天津独资的丹麦NOVO公司投入生产,这给国内各酶制剂生产厂家带来更大的竞争压力。
如今,大多数酒精生产厂已不再自行生产淀粉酶与糖化剂,而是从专门的生产酶制剂的厂家直接购进,因此,本书不再详细介绍酶的生产条件等,而就几种重要的酶制剂进行介绍。
3.2.4.1 α-淀粉酶
淀粉酶是水解淀粉酶和糖原酶类的统称,是最早实现工业化生产,迄今为止用途最广、产量最大的酶制剂品种。来源不同的液化型淀粉酶(α-淀粉酶)对酒精生产极为重要,但很多生产厂家重视糖化酶而忽视了液化酶的作用。其实在生产过程中,液化作用并不逊于糖化作用,它不仅使淀粉糊液化,同时重要的是对颗粒物质的溶解。
液化型淀粉酶来源不同,其作用、特性亦不同。在一般情况下,α-淀粉酶主要从动物及细菌获得,霉菌一般糖化能力强而液化能力偏低。而麦芽却有极强的β-淀粉酶及糖化淀粉酶,生产上所用麦芽的淀粉酶都不是纯品,是多种酶的混合体,只是以某种酶为主罢了。酿造工业上所用的是混合酶,由于酶的协同作用结果,反而比单一酶的效果更好。
近年来发现许多种新型淀粉酶(其中包括α-淀粉酶),有耐酸性淀粉酶,耐热性淀粉酶,适于碱性的淀粉酶和专门糖化生淀粉的淀粉酶等。由于对淀粉酶的深入研究与发展,不但开辟了新型工业(如普鲁兰糖,环状糊精等),并对研究淀粉结构也起到了重要作用。而且转基因技术发现了许多微生物新品种和新机能的代谢产物,在此基础上进行淀粉酶的切断方式及提高淀粉酶活力的研究,已经取得了新的进展。
1、高温α-淀粉酶
通常是指具有较高最适反应温度的淀粉酶,是淀粉加工中有重要用途的一种酶,广泛应用于酿酒、食品、医药、纺织和环境治理等行业,已经成为工业上用量最多的酶之一。能产生高温α-淀粉酶的菌种主要是芽孢杆菌属的凝结芽孢杆菌(Bacillus
coagulans)、枯草芽孢杆菌(B.
subtilis)、嗜热芽孢杆菌(B.
stearothermophilus)、地衣芽孢杆菌 (B.
licheniformis}和属于古细菌的Pyrococcus
furiosus,Pyrococcus
woesei,Thermococcus
profundus等,目前工业生产中使用的高温淀粉酶主要来自地衣芽孢杆菌及其突变株。
该酶制剂是一种内切淀粉酶,能在较高温度下随机水解淀粉、可溶性糊精及低聚糖中的α-1,4-葡萄糖苷键。酶作用后可使糊化淀粉的粘度迅速降低,变成液体淀粉,水解生成糊精和少量葡萄糖、麦芽糖。其适用条件为85~97℃ ,pH 5.5~7.0。
2.中温α-淀粉酶
中温α-淀粉酶在作用淀粉时,能以随机的方式从淀粉分子内部切开α-1,4葡萄糖苷键,使淀粉分解成长短不一的短链糊精和少量的低分子量糖类,从而使淀粉醪液的粘度显著下降,达到液化淀粉的作用,故又称为液化酶。其作用条件为60~70℃ ,pH6.0~7.0。
3.2.4.2 β-淀粉酶
β-淀粉酶可以从多糖分子的非还原性末端,每隔2个葡萄糖苷切割α-1,4葡萄糖苷键,生成麦芽糖。由于该酶水解淀粉只能到分枝点(支链淀粉的α-1,6葡萄糖苷键)或反常键(直链淀粉的α-1,3葡萄糖苷键)为止,因此淀粉和β-淀粉酶作用的产物除了麦芽糖外,还有极限糊精。在谷物的支链淀粉水解时,极限糊精含量可达42%。
β-淀粉酶的分子量大约为57000。最适宜作用的pH值为5,但在4~6.5之间可以保持90%活性。温度为55~57℃时活性最高,60℃以上活性急剧下降。重金属Ag+,Cu2+,Hg2+等能与该酶的硫代基团作用,所以是抑制剂。
3.2.4.3 外切-1,4-α葡萄糖苷酶(葡萄糖淀粉酶,淀粉葡萄糖苷酶)
该酶可以从多糖的非还原性末端连续切割α-1,4葡萄糖苷键,也可分解α-1,6葡萄糖苷键,甚至还能分解α-1,3葡萄糖苷键,但分解后两种键的速度较慢。因此该酶可以将淀粉、糊精和麦芽糖完全转化成葡萄糖,是酒精生产中淀粉糖化过程所需的关键性酶,即所谓的糖化酶。
该酶的产生菌主要是霉菌,特别是黑曲霉。其分子量大约为95000,最适宜的pH值为3.5~4.5,在pH值为3.0~5.5之间能保持80%的活性。60~65℃之间活性最高,但高过60℃,活性迅速下降。pH4.2,温度60℃,保持1小时,仍能保持75%的活性。
以上三种酶是酒精生产过程中使用的淀粉酶系统的最重要的组成部分。
3.2.4.4 酶的作用机理
酶的作用是在溶液状态下进行的,特别是水解酶类的作用更需要有水的参与。由于淀粉颗粒外层的网络结构极为致密,水分子要进入淀粉分子中去是很困难的,这就不利于淀粉酶的作用。传统生产工艺中,糊化的目的是利用温度破坏淀粉分子间的氢键,切断淀粉链。同时,每个淀粉分子链上借氢键维系的螺旋型空间结构也被破坏,链被拉长。这就更利于淀粉酶能充分与淀粉分子接触,从而水解淀粉。因此,淀粉是否经过糊化和糊化程度是否彻底,直接影响其水解速度。酶切断淀粉分子,使其转化为低聚糖、麦芽糖以及葡萄糖等小分子,这一过程受很多因素的影响,下面以酒精生产糖化工艺中两种重要酶系:耐高温α–淀粉酶和糖化酶为例分析各影响因素。
1.耐高温α–淀粉酶
α–淀粉酶能水解淀粉及其产物分子中的α–1,4葡萄糖苷键,生成产物的还原末端葡萄糖残基中C1为α–构型。α–淀粉酶不能水解淀粉分子中的α–l,6葡萄糖苷键,但能越过此键继续水解α–1,4葡萄糖苷键,而将α–1,6键存留在水解产物中。α–淀粉酶水解淀粉是从淀粉分子内部进行的,随机水解淀粉链中的α–1,4键。糖苷键C1–O–C4的裂解在C1-O间进行,水解作用的最终产物因不同淀粉及作用时间而异。α–淀粉酶水解直链淀粉分子,最后阶段产物为葡萄糖、麦芽糖和麦芽三糖;在加酶量大、作用时间长的情况下,麦芽三糖也能被水解为麦芽糖和葡萄糖。α–淀粉酶水解支链淀粉,除了具有直链淀粉的水解产物外,在产物中还有异麦芽糖和含有α–1,6键的低聚糖(支链的分枝点存在α–1,6键)。α–1,6键的存在常使淀粉的水解速度减慢。
耐高温α–淀粉酶是一种淀粉内切酶,能随机水解淀粉、可溶性糊精及低聚糖中的α–1,4葡萄糖苷键。该酶可使糊化淀粉的黏度迅速降低,故又称淀粉液化酶,水解产物有糊精及少量葡萄糖和麦芽糖。
pH对酶活力及酶稳定性的影响 耐高温α–淀粉酶最适pH范围为5.5~7.0,稳定pH范围为5.0~10.0,有效pH范围为5.0~8.0。pH对酶活力和酶稳定性影响见图3–8、图3–9。

在液化工艺中,大型酒精企业均采用酒糟清液回用工艺,因酒糟清液酸度较高,需用碱液调整其pH至6左右,以利于保证α–淀粉酶的活性。
温度对酶活力及酶稳定性的影响 在淀粉的液化喷射过程中,耐高温α–淀粉酶在高温下酶的活力稳定,酶的热稳定性也相当好,可用于淀粉的间歇液化和连续液化过程。其最适作用温度在90℃以上(连续喷射液化中,耐热温度可达100~105℃。酶是一种蛋白质,一般蛋白质在60℃即失去活性,耐高温α–淀粉酶却能在高温下保持非常高的活力,这一机理有待深入研究)。温度对酶活力及酶稳定性的影响见图3–10、图3–11。

温度对酶活力及酶稳定性的影响 糖化酶最适作用温度范围为58~60℃(可作用温度范围为40~65℃)。糖化酶的温度对酶活力及酶稳定性的影响见图3–14、图3–15。

抑制剂对酶作用的影响 大部分重金属,如铜、银、汞、铅等都能对糖化酶产生抑制作用。



